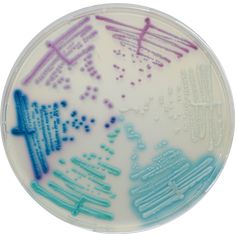

CA243-25
For detection and differentiation of major clinical Candida species, including C. auris
Package size: 25 L
DKK 13.125,00
DKK 3.000,00
Not in stock, delivery 1-2 weeks
Chromogenic medium for detecton and diferentaton of major clinical Candida species, including C. auris.
The product is composed of a powder base.
MEDIUM PERFORMANCE:
1. High Specificity: Differentiation of the most common Candida species with ≈ 100 % specificity to C. albicans, C. tropicalis and C. krusei*
2. Unique medium to differentiate C. auris from other Candida species: Owe to its high specificity, it can be used also as a screening tool in case of outbreaks. Specificity≈ 100 %* Sensitivity ≈ 100 %*
*Specificity and Sensitivity from scientific study: «Evaluation of a novel chromogenic medium for Candida spp. identification and comparison with CHROMagar™ Candida for the detection of Candida auris in surveillance samples» Juan V. Mulet and al., 2020.
3. Easy identification: Identification by MALDI-TOF can be carried directly from a colony. No need of subculture.
TYPICAL APPEARANCE OF MICROORGANISMS:
Candida albicans → green-blue
Candida auris → light blue with blue halo
Candida tropicalis → metallic blue with pink halo
Candida krusei → pink and fuzzy
The Candida are yeasts involved in various infections called Candidiasis, which can affect damaged skin, respiratory tract, digestive and urogenital systems. These Candidiasis can be severe with signifcant morbidity for nosocomial infections or in immunocompromised patients.
Although C. albicans is still the main species involved, the use of antifungal agents has given rise to other species such as C. tropicalis, C. krusei and C. glabrata. In 2016, The World Health Organization added to this list C. auris, with a prevalence of over 90 % resistant to fuconazole. In addition, some strains are multidrug resistant to amphotericin B, voriconazole, and/or echinocandins.
t is recommended to carry out an early diagnosis of Candida in order to provide specifc treatment as quickly as possible. Candida can be isolated by swabbing the skin, throat, rectum, or urogenital tract.
CHROMagar™ Candida Plus is the frst chromogenic isolation medium to detect and differentiate C. auris in addition to other major clinical Candida species such as C. albicans, C. tropicalis, C. glabrata or C. krusei.
Also available in 25 L (CA243-25). Bulk on request.